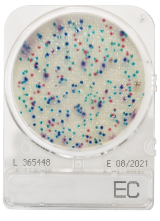
CompactDry EC - E. coli and coliform

Compactdry | SKU:
2192007
CompactDry EC - E. coli and coliform
Reguliere prijs
€57,39
Eenheid prijs
Waarom bestellen bij Antonides?
✅Persoonlijk en betrouwbaar
✅Flexibel en op maat
CompactDry EC biedt een snelle en betrouwbare test voor E. coli en coliforme bacteriën in voedingsmiddelen en water. Kleurverandering maakt het tellen eenvoudig.
-
Merk
-
Merk artikelnummer
Afbeeldingen dienen ter illustratie. Product kan afwijken van de getoonde foto.